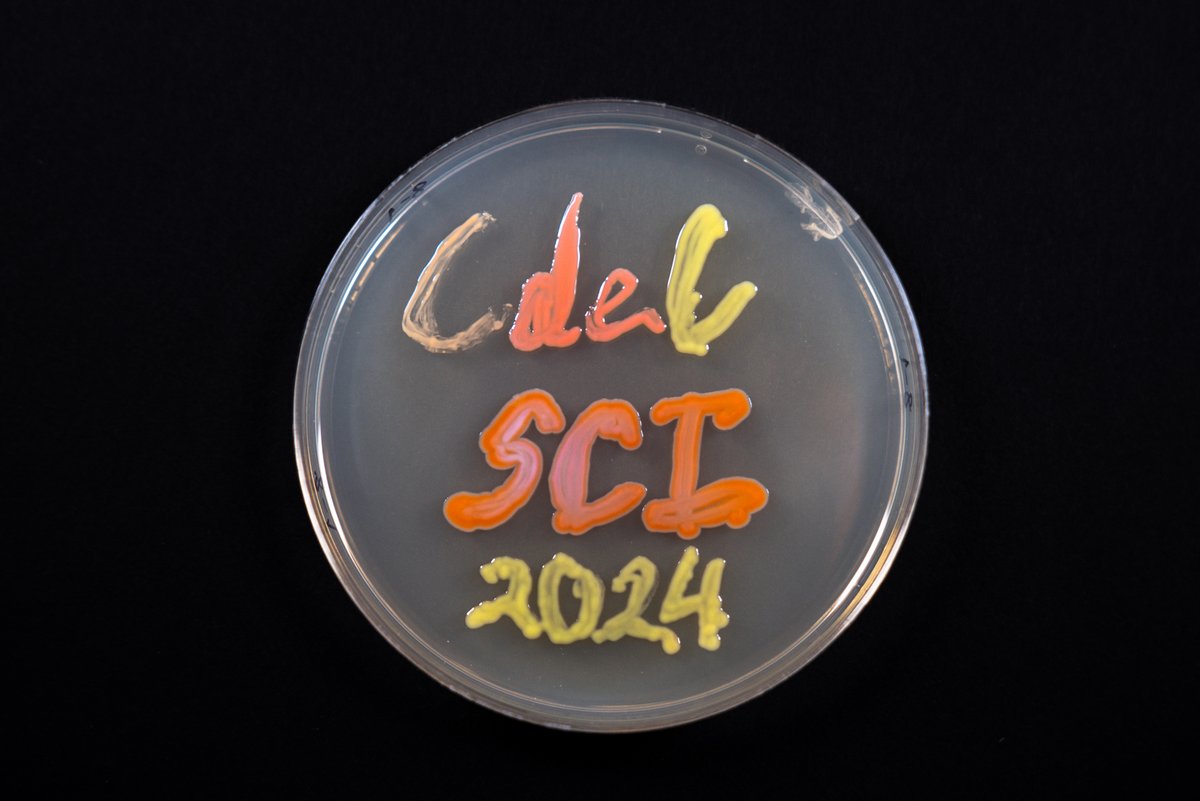
Science Clubs International tweet media

Sabitlenmiş Tweet

Expresamos nuestro rechazo enérgico a las declaraciones del congresista @ErnesBustamante que desde la ignorancia, rechazo a la evidencia y estereotipos atribuye la menor participación de mujeres en ciencia a supuestas "características biológicas". Más en: acortar.link/hgAOke

Español